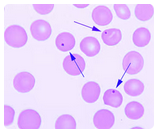

ASCP ASCP-MLT - MEDICAL LABORATORY TECHNICIAN - MLT(ASCP)
Where can one find guidance on the minimum performance standards for clinical laboratories?
The clue to the identification of the colony seen in the upper frame is the gram stain in the lower frame, in which are seen short, rounded, gram positive bacilli, many of which possess distinct spores. As the colonies grew aerobically, the presence of spores indicates Bacillus species. The colonies are spreading, smooth, yellow-white and non-hemolytic. The lack of hemolysis and the small size of the bacterial cells suggests a species other than Bacillus cereus, the species causing most human infections. The isolate was identified as Bacillus circulans, which is consistent with the gram stain morphology. Clostridium septicum also produces spores; however, this species is an anaerobe and would grow poorly if at all and not produce spores aerobically. Listeria monocytogenes and Lactobacillus species are gram positive bacilli; however, neither of these produce spores.
The colonies seen in the upper frame, grown after 48 hours incubation aerobically at 35°C, and the accompanying gram stain in the lower frame are uncommonly associated with human disease, but have been associated with septicemia, bronchopneumonia, osteomyelitis and other infections, particularly in intravenous drug users. The most likely identification is:

Plasma concentrations of creatinine are used to assess renal function. Creatinine clearance is based on the serum creatinine level and is used to measure glomerular filtration rate, or GFR.
An increased serum level of which of the following analytes is MOST commonly associated with decreased glomerular filtration?
The concentration of circulating ferritin is proportional to the size of iron stores.
Which of the following will give the best overall picture of a patient's iron stores:
Valine substitutes for glutamic acid in the Beta 6 position to produce HbS.
To produce hemoglobin S, glutamic acid that is normally present in the sixth position on the beta globin chain is substituted with which of the following?
Refrigerated temperatures, those close to 4 ºC, are recommended for the preservation of enzyme activity in a patient sample.
Chemistry
The recommended storage temperature for the preservation of activity for MOST enzymes is:
Western blot analysis is frequently utilized as the confirmatory method of HIV detection.
Which of the following assays is routinely used for confirmation of HIV infections:
What is the first thing a phlebotomist should do in the event of an accidental needle stick?
An antithetical relationship exists between the antigens M and N. Antithetical relationships occur in situations where for a given locus, only one of two genes may be inherited, the alleles are termed antithetical alleles.
In immunohematology, an antithetical relationship exists between M antigen and which of these antigens?
Neutrophils, lymphocytes and macrophage/ monocytes can be found in all types of body fluid differentials. Bronchial cells can be found only in bronchial washings and BAL specimens. Mesothelial cells are found only in serous body fluids including pleural fluid, peritoneal fluid, and pericardial fluid.
Select the specific cells listed below that can be found in all types of body fluid.
The microscopic features shown here represent Scopulariopsis species. In most instances, particularly if a patient does not have underlying immunologic or hematologic disease, Scopulariopsis species should be considered a contaminant when recovered from a sputum specimen. However, if there is clinical or X-ray evidence of mycotic pulmonary infection, additional daily induced sputum specimens should be obtained.
If Scopulariopsis species or any other hyaline mold is recovered from two or more successive specimens, its potential as a pathogenic agent should be considered. Scopulariopsis species have been reported as the agents of pulmonary fungus ball infections in patients with preexistent cavities and as a cause of pneumonia in patients with leukemia.
Invasive pulmonary disease by this agent has not been reported.
The fungus illustrated in this photomicrograph was recovered from an induced sputum specimen from a 74 year old man with chronic obstructive pulmonary disease. This isolate is most likely:

The most common specimen analyzed in the hematology section is:
Howell-Jolly bodies are composed of DNA and appear as small round ball-like inclusions inside the red cells. Usually only one Howell-Jolly body will be present in each red cell.
Single erythrocyte inclusions which are large, round, smooth and purplish-blue staining are most likely:
Antibodies are differentiated based on their heavy chains; different heavy chains create different isotypes. Humans have five different isotypes of immunoglobulins.
Immunology
The part of the molecule responsible for differences among immunoglobulin classes is:
In the laboratory, surfaces must be disinfected for blood spills. What is the most common disinfectant used?
